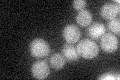
YJR011C
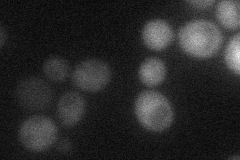
YJR011C
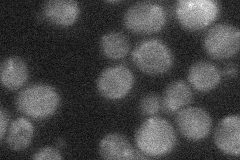
YJR011C
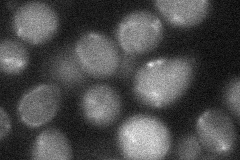
YJR011C
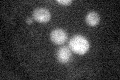
YJR011C
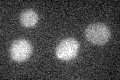
YJR011C

View description
Putative protein of unknown function; GFP-fusion protein expression is induced in response to the DNA-damaging agent MMS
Localization:
Intensity:
Fold change:
Significance:
-
C’ GFP library in SD
below threshold16.93 -
N' NOP1pr-GFP in SD

cytosol75.0502 -
N' TEF2pr-mCherry in SD
cytosol22.1341 -
N' NATIVEpr-GFP in SD
below threshold22.8565 -
N' TEF2pr-VC and Cyto-VN in SD
below threshold27.1048 -
C’ GFP library in SD+DTT
cytosol16.380.96No -
C’ GFP library in SD+H2O2

cytosol17.021No -
C’ GFP library in Starvation Media
cytosol14.440.85No -
C’ GFP library on the background of Pup2-DaMP

below threshold -
C’ GFP library on the background of CCT mutant

below threshold18.87251.11425No
